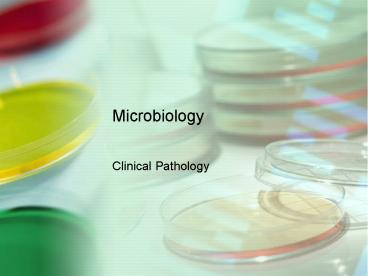

Microbiology PowerPoint PPT Presentation
Title: Microbiology
1
Microbiology
- Clinical Pathology
2
Microbiology
- The study of microscopic organisms
- Clinical microbiology is the identification of
these organisms that cause clinical illness
3
Laboratory Safety
- Most microorganisms are potentially pathogenic
- DO NOT EAT OR DRINK IN LAB!
- Clean area with disinfectant at beginning and end
of the work period - Avoid putting any object in mouth (pencil,
fingers). - Tape shut all containers of cultures before
disposal. - Flame wire loops immediately after use.
- Always use aseptic technique
4
Laboratory Safety Continued
- Place contaminated materials in appropriate
containers for disposal. - Never use a mouth pipette.
- WASH HANDS
- REPORT ALL LABORATORY INCIDENTS IMMEDIATELY!!!!
5
Equipment and Supplies
- Incubator
- Sterilizing heat source
- Bunsen burner
- Heating element
- Alcohol lamps
- Media
- Microscope
- Antimicrobrial sensitivity discs
- Miscellaneous other equipment
- Metal loop
- Slides
- Sterile cotton tip applicators
- Wax markers
- Stain
6
Incubators
- Allows organism to be grown under controlled
conditions - Keeps specimen at 37 C (98.6 F)
- Human body temperature and room air Oxygen
- Most cultures are grown overnight and held at
least 48 hours.
7
Sterilizing Heat Sources
- Bunsen Burner
- Sterilizes metal loop used for transferring
organisms to be inoculated into growing media - Electric heating element
- Usually ceramic, an enclosed heater.
- Eliminates the need for a natural gas
- Alcohol lamps
- Less expensive
- Glass lamp with wick
- Does not sterilize metal loops that quickly
8
(No Transcript)
9
Media
- Nutritive media- grows all types of bacteria
- Selective media- grows only certain types of
bacteria - Gram negative or gram positives
- Enriched media- basic nutrient media with extra
nutrients added-blood, serum, or egg. - Differential Media- contains elements that
differentiate certain types of bacteria (ex.
Lactose fermenters or hydrogen sulfide producers)
10
Media Continued
- Examine media for accidental bacteria/fungal
contaminants before use - Incubate al plates UPSIDE DOWN
- Prevents condensation from dripping onto
cultures. - Media may be solid (agar) or liquid (broth).
- Plate is a flat, round container of agar
- Tube is a screw-top container that may contain
broth and agar - Slant, a tube of agar that has been allowed to
gel at an angle.
11
Basic Nutrient Media
- Peptone- hydrolyzed protein that can be
metabolized by bacteria (provides AA) - Principal nutrient of the medium
- Salt
- Dextrose- gives carbon and energy for bacteria
- Water
- Meat extract- provides water soluble CHO nitrogen
and vitamins - Solidifying agents- Agar, gelatin
- Basic Nutrient Types
- Nutrient Agar
- Trypticase soy agar (TSA)
12
Selective Media
- Blood Agar
- Chocolate Agar
- Media supports most bacterial pathogens
13
Blood Agar
- TSA 5 sheep blood
- Can refer to Blood Agar Plate (BAP)
- Blood agar should be bright red
- Brownish-red color may indicate
- Blood is too old, RBCs are hemolyzing
- Blood was added to the agar base when the medium
was too hot - Inadequate mixing of blood and agar
14
Blood Agar Continued
- Also acts as a differential media
- Four types of hemolysis
- Alpha hemolysis- partial hemolysis
- Narrow band of greenish slimy discoloration
around the colonies - Beta hemolysis- complete hemolysis
- Clear zone around the bacterial colony
- Gamma hemolysis- no hemolysis
- Delta hemolysis- Double zone hemolysis
- Double ring of hemolysis around colonies
- Can differentiate different species of
Streptococcus.
15
(No Transcript)
16
Chocolate Agar
- For Hemophilus spp.
- A very nutritive media
- Hemolyzed RBCs with growth factors
- Has increased Carbon dioxide
17
MacConkey Media
- Both a selective and differential media
- Selects for Gram-negative
- Uses crystal violet as a gram inhibitor
- Suppresses growth of gram
- Indicators
- Lactose and neutral red
- Lactose fermentors (E. coli, Enterobacter, and
Klebsiella) produce acid from lactose and grow as
pinkish-red colonies - Lactose non-fermentors- produce colorless
colonies - Ex. No growth on MAC and good growth on BAP
suggests Gram - Inhibits swarming of Proteus
18
Enriched Media
- Brain-heart Infusion Broth (BHIA)
- Mueller-Hinton agar (MH)
- For antibiotic sensitivity
19
Brain-heart Infusion Broth (BHIA)
- General purpose broth used to increase the
numbers of organisms before they are plated - Ex. Listeria from brain tissue may be difficult
to grow, finely cut brain tissue is incubated for
weeks in BHIA, then cultured.
20
Differential Media (several types)
- Urea agar slant
- Will turn from peach to pink with ammonium
production - Triple sugar iron agar
- Have lactose, sucrose, glucose
- Differentiates- Salmonellas and other enteric
bacteria - Mannitol salt agar
- For select Staph species
21
Inoculating Culture Media
- Use sterile technique
- Flame neck of tube when transferring organisms.
- Do not put the cap down but hold between last 2
fingers - Flame the near portion of the wire 1st, then work
towards the contaminated end - Turns red
- Prevents bacteria splatter
22
Streaking Plates
- Flame the bacterial loop between and cool
- Each streak is overlapped only 1-2 times to avoid
depositing excessive numbers of bacteria - Will give discreet isolated colonies
- Use the entire plate to streak
- Turn plate for each streak
- Flame/cool loop in between
23
Materials you will need
- Gloves
- Inoculating loop OR sterilized wooden sticks for
streaking - Permanent marker or grease pencil to label your
plates beforehand - Bunsen burner or sterilizing heater if intending
to sterilize the inoculating loop between streaks - Swab for collecting the primary inoculum, if
intending to collect bacteria from an
environmental source - Agar plate
- Incubator, if incubating at a controlled
temperature, such as 37?C. However, many common
microbial species will grow on plates left at
room temperature, through their growth may be
slower than if the plates were incubated at 37?C - Antibacterial soap to wash your hands
- 5 bleach solution to clean your work area when
finished.
24
Step One (The Primary Streak) If you are
right-handed, hold the plate in your left hand,
and the inoculating loop in your right - as
through you would a paint brush. If you are
left-handed, use the opposite hands.
Touch your inoculating loop (sterile swab, or
sterile stick as shown in the picture) to the
material you want to spread. Go back and forth
a number of times in a small area of the Agar
plate. The goal is to spread your material
completely over this inital area of the plate.
25
Step Two(The Secondary Streak)Sterilize your
inoculating loop, or use a fresh, sterile
inoculating stick or swab. Make sure the loop is
cool before your next streak. If you were to use
the original loop, you will not be diluting the
individual microbes you applied in the first
streak.
- Pick up the plate and rotate it 1/4 of a turn to
your left (if right-handed), or to your right (if
left handed). - Run the loop through the previous streak 2-3
times, then draw it along 1/3 of the remaining
plate, as shown by the blue line in the image.
26
Step Three(The Tertiary Streak) Rotate the
plate another 1/4 turn and sterilize
yourinoculating loop or take a fresh, sterile
stick or swab. Again, make sure to cool your loop
between streaks.
- Run the loop through the previous, secondary
streak 2-3 times, and draw the streak over a
remaining 1/3 of the plate, as shown.
27
Step Four(The Quarternary Streak)Rotate the
plate another 1/4 turn and sterilize the
inoculating loop. Again, cool the loop between
streaks, or use a new sterile swab.
- Run the loop through the previous tertiary
streak 2 times and draw over the remaining free
space in the plate, being careful not to contact
the primary streak (yellow).
28
Inoculating Slants
- Only the surface
- Streak S shaped
- Both surface and butt
- Stab the butt
- Withdraw the wire up same insertion path
- Then streak the slant
29
Colony characteristics
- Size- pin point, medium, large
- Color- yellow, white, gray, cream, etc.
- Density- opaque, transparent
- Elevation-raised, flat, convex, droplike
- Form-circular, irregular
- Consistency- buttery, brittle, sticky
- Odor- pungent, sweet, etc
- Hemolysis- alpha, beta, gamma
30
Form
- What is the basic shape of the colony? For
example, circular, filamentous, etc.
31
Elevation
- What is the cross sectional shape of the colony?
Turn the Petri dish on end.
32
Margin
- What is the magnified shape of the edge of the
colony?
33
Surface
- How does the surface of the colony appear? For
example, smooth, glistening, rough, dull
(opposite of glistening), rugose (wrinkled), etc.
34
Opacity
- For example, transparent (clear), opaque,
translucent (almost clear, but distorted vision,
like looking through frosted glass), iridescent
(changing colors in reflected light), etc.
35
Chromogenesis (Pigmentation)
- For example, white, buff, red, purple, etc.
36
Bacterial Staining
- Grams stain
- Acid fast stain
- Geimsa stain
- Examine number, types of bacteria
37
Gram Staining
- Used to categorize bacteria as Gram or Gram -.
- Use cell wall morphology
- Use young colonies (24 hours old)
- Older colonies may not give proper results
- Decolorization
- Bacteria that retain the crystal violet-iodine
complex stain Purple are Gram - Those that lose the crystal violet and stain Red
by safarin or basic fuschsin are Gram -
38
(No Transcript)
39
Gram Staining
- Obtain a sample from one colony with sterile wire
loop - Mix with drop of saline or water on the slide, if
from broth use 2-3 loopfuls - Circle the area with wax pencil
- After drying, heat fix- DO NOT overheat
- Prevents bacteria from washing off
- Kills bacteria and makes them pick up stain
40
Gram Staining
- Exam also morphology
- Bacilli
- Cocci
- Coccobacilli
- Spiral
- Paris, chains, clusters
- Sometimes get a Gram variable reaction
- Both Gram and Gram on same organism
41
Gram variable
- May occur because
- Excessive heat fixation
- Decolarization
- Overly thick smear
- Old cultures
- Poor quality stain
42
Potassium Hydroxide Test (KOH)
- Checks the gram reaction
- Place a loopful of 3 KOH on slide
- Place a large amount of surface growth
- Stir, then slowly lift loop up after 30 seconds
- Gram neg- sticky strand
- Grand - does not form a strand on lifting
43
Size/shape/arrangement
- Cocci- spherical in shape
- Staph aureus
- Bacillus- rod in shape
- Bacillus anthracis
- Spiral-
- Loose spirals- Borrelia
- Tight spirals- Leptospira
- Comma shaped spirals- Campylobacter
44
Bacterial arrangement
- Single- most bacilli
- Pairs- Streptococcus pneumoniae
- Clusters- Staph aureus
- Chains- Strep species
- Palisades- Chinese letter pattern- Corynebacteria
45
Acid Fast stain
- Several types of stains
- Used to detect Mycobacteria and Nocardia
- Acid fast bacteria- stain red
- Non acid fast- stain blue or green
- Depends on stain used- brilliant green or
methylene blue
46
Giemsa stain
- Used to detect spirochetes and ricketssiae
- Demonstrates the capsule of Bacillus anthracis
47
Procedure for Identifying Bacteria
- Streak on Blood agar and MAC
- Incubated 18-24 hours
- Select colonies from BAP vs. MAC
- MAC may inhibit some colonies
- Gram stain
- Differential media
48
Gram Positive Cocci
- Staphylococci
- Steptococci
- Micrococci
49
Catalase Test
- Do when have a gram positive cocci and small gram
positive bacilli (any gram positive colony) - Tests for the enzyme catalase, which acts on
hydrogen peroxide to produce water and oxygen. - Place a small amount of an isolated colony from a
blood agar plate on slide and a drop of catalase
reagent (3 hydrogen peroxide). - Catalase positive- gas bubbles are produced
- Catalase negative- no gas bubbles are produced
- Do not transfer any blood agar with colony
because may get a slightly positive reaction
50
(No Transcript)
51
Coagulase Test
- Do when have a catalase positive, Gram positive
cocci - Some Staph species have an enzyme that coagulate
plasma. - In general, the coagulase positive staph are more
pathogenic - Staph aureus and Staph intermedius are coagulase
positive - Staph epidermidis is coagulase negative
52
Tube Coagulase test
- Tube coagulase test- lypophilized plasma is
placed in a test tube with a loopful of colony - Positive reaction- has clots after 4 hours
- Slide coagulase test- loopful of colony is
emulsified in a drop of saline. A drop of rabbit
or human plasma is added - Positive reaction- clumping in 5-20 seconds
53
Staphylococci
- Gram positive cocci
- Staph aureus- often in grape-like clusters
- Catalase test positive
- /- Coagulase positive
- Staph aureus is coagulase positive
- Staph aureus- abcesses, wound infections,
mastitis - Staph epidermidis- usually non-pathogenic skin
- Staph intermedius- Skin infections
- Staph hyicus- greasy pig disease, exudative skin
lesions
54
Streptococci
- Gram positive cocci
- Pairs- Strep penumoniae
- Chains
- Catalase negative
- Note hemolysis in blood agar
- Several strep species may be responsible for many
illnesses including pneumonia, mastitis,
septicemia, and enteritis. - Several strep species may cause neonatal
septicemia, urinary infections, pneumonia - Strep fecalis- (enterococcus). Opportunistic
pathogen found in the GI tract - Strep equi- Strangles (pus, abscesses, enlarged
lymph nodes) - Other strep equi subgroups may cause mastitis,
abortion and abscesses.
55
Gram negative Cocci
- Moraxella bovis- large gram negative cocci that
resembles fat rods (coccobacillus) - Causes pink eye in cattle (Keratoconjunctivitis)
- Neisseria spp. Often found in respiratory tract
of many normal animals - N. gonnohoeae- human gonnorhea
56
Gram positive rods
- Aerobic and anaerobic Gram rods
- Anaerobic- need specific collection device
- THIO (thiglycollate broth) grows anaerobes
- Some Gram rods produce spores
- Bacillus and Clostridium are sporeformers
- Spores vary in shape, size, and location
- Non-staining bodies on the Gram stain
57
Spores (Endospores)
- Central Bacillus anthracis
- Subterminal Present near the end
- Terminal Present at the end
- Clostridium tetani
58
Gram positive Rods species of concern
- Bacillus anthracis- causes sudden death in cattle
and sheep (Fatal septicemia), in humans will
cause skin and lung lesions - Bacillus cereus- can cause food poisoning
- Bacillus piliformis- acute fatal enteritis in
rodents and foals - Clostridium botulinum- botulism
- Clostridium Chauvoei- Blackleg (gas gangrene)
- Clostridium perfringens- gangrenous necrosis of
the skin, entertoxemia/pulpy kidney disease of
sheep - Clostridium tetani- tetanus
- Corynebacterium equi- foal pneumonia
- Corynebacterium pseudotuberculosis- casseous
lymphadneitis in sheep - Corynebacterium renale- UTI in cattle
59
Gram negative Rods
- Grow on MAC
- Note the lactose reaction of the colony
- Do oxidase test if non-lactose fermentor
- All lactose fermentors are oxidase negative
- Enteric (gut bacteria) pathogens and non
pathogens (opportunistic)
60
Oxidase test
- Oxidase reagent is added to filter paper with
colony sample - Positive will change to purple color in 60 sec.
- Oxidase test can differentiate between gram
negative bacteria within 2 groups - Pseudomonas- oxidase positive
- E. coli- oxidase negative
61
Gram Negative Rods
Oxidase Positive Oxidase Negative
Patuerella Enterobacteriaceae
Bordetella E. Coli
Pseudomonas Shigella
Actinobacillus Salmonella
Hemophilius Proteus
62
Gram Negative Coccobacilli
- May be difficult to tell from cocci
- May not grow on MAC
- Moraxella
- Brucella-
- Brucellosis canis- abortion, diskosponylitis
- Brucella abortus- cattle
63
Higher/Resistant Bacteria
- Mycobacterium
- Mycobacterium tuberculosis- pneumonia in humans
and primates - Mycobacterium avium- GI/respiratory infections in
birds - Mycobacterium paratuberculosis- Johnes disease
of cows, sheep and goats - Nocardia
- Purulent lesions in dogs/cats
- Long branching filamentous rods
64
Spirochetes
- Leptospira
- Campylobacter
65
Antimicrobial Susceptibility Testing
- Performed when bacteria are isolated from a
patient - Determines the susceptibility or resistance to
antibiotics - Ideally, the specimen used for the susceptibility
testing should be collected prior to treatment
with antibiotics. - Must isolate the suspected pathogen
- Gram stain-
- Some antibiotics are more effective against Gram
or Gram - bacteria
66
Terminology
- Antibiotic- a biologic substance developed from a
microbe that is either bacteriostatic or
bacteriocidal. Most antibiotics are produced from
molds, but a few are produced from bacteria. - Bacteriocidal- kills bacteria
- Bacteriostatic- drug inhibits a bacterias growth
but does not kill the bacteria - Antibiotic resistance- the aquired ability for a
bacteria to grow in the presence of an
antibiotic. - Antibiotic therapy aims to treat infection with a
drug that the causative bacterial pathogen is
sensitive to.
67
Antimicrobrial Susceptibility Testing
- Agar diffusion method
- Most commonly used
- Uses paper discs impregnated with antimicrobials
- Requires measurement of zone sizes to give an
estimate of the antibiotic susceptibility (zone
of inhibition)
68
Kirby-Baur Antimicrobial Testing Method
- Uses Mueller-Hinton blood with or without 5
blood - Make sure there is no gross moisture on the agar
surface or lid before use. - Grows most bacteria, but with Strep, usually have
to use the blood additive
69
Kirby- Bauer Method Preparation of Bacteria
- Preparation of the bacteria
- 1. Need to standardize the bacterial sample
- 3-4 well isolated colonies are obtained with
sterile loop and placed in 3 ml tube of sterile
saline - 2. Inoculate the Mueller-Hinton agar with the
suspension using sterile cottonswab - Be sure to streak the entire plate evenly in
several directions - Streak the plate 3 times at 120 degree angles
- Allow to dry for 15-30 minutes
- 3. Application of antibiotic paper discs
- Using a disk dispenser, apply the disk to the
agar surface - Apply slight pressure with sterile forceps to
ensure the disks will adhere to the surface - 4. Incubate for 18-48 hours
- 5. Measure the zones of inhibition with mm ruler
70
(No Transcript)
71
Kirby-Bauer Method Reading Zones of Inhibition
- Read the zone size from the top surface with the
lid of the plate removed - Zone sizes are divided into 2 major categories
- Resistant
- Susceptible
- Intermediate susceptibility implies that at
higher dosages the bacteria may be susceptible
72
Abscesses
- Small Animals
- Staph aureus
- Steptococci
- Pastuerella multocida (from bite wounds)
- Pseudomonas aeruginosa
- Large Animals
- Corynebacterium pyogenes
- Corynebacterium pseudotuberculosis
- Strep
- Staph and Pseudomonas
73
Lumpy Jaw and Wooden Tongue
- Infections caused by Actinomyces bovis and
Actinobacillus lignieresi in cattle - Abscesses in the jaw region
- Has granules in the pus
74
Other diseases of interest
- Brucellosis
- Causes abortions in many species
- Brucella abortus, canis, ovis, suis
- Mastitis
- Staph aureus, strep agalactiae, e.coli,
corynebacterium, pseudomonas, pastuerella - UTI (small animal)
- E. coli, proteus, staph aureus, pseudomonas,
enterobacter - Bordetella
- Bordetella bronchiseptica